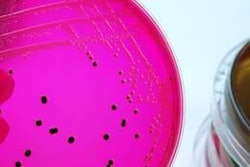

On Thursday, February 10, CNBC will air a documentary that goes inside the US$16 billion dollar petfood industry to determine what caused thousands of dogs and cats in North America to become seriously ill in 2007.
"Pet Food: A Dog's Breakfast," will examine regulation in the petfood industry, trying to answer the question, is petfood safe? The documentary will premiere on CNBC February 10 at 10 p.m Eastern Standard Time. It will repeat Friday, February 11 at 1 a.m. EST and again on Sunday, February 13 at 10 p.m. EST.